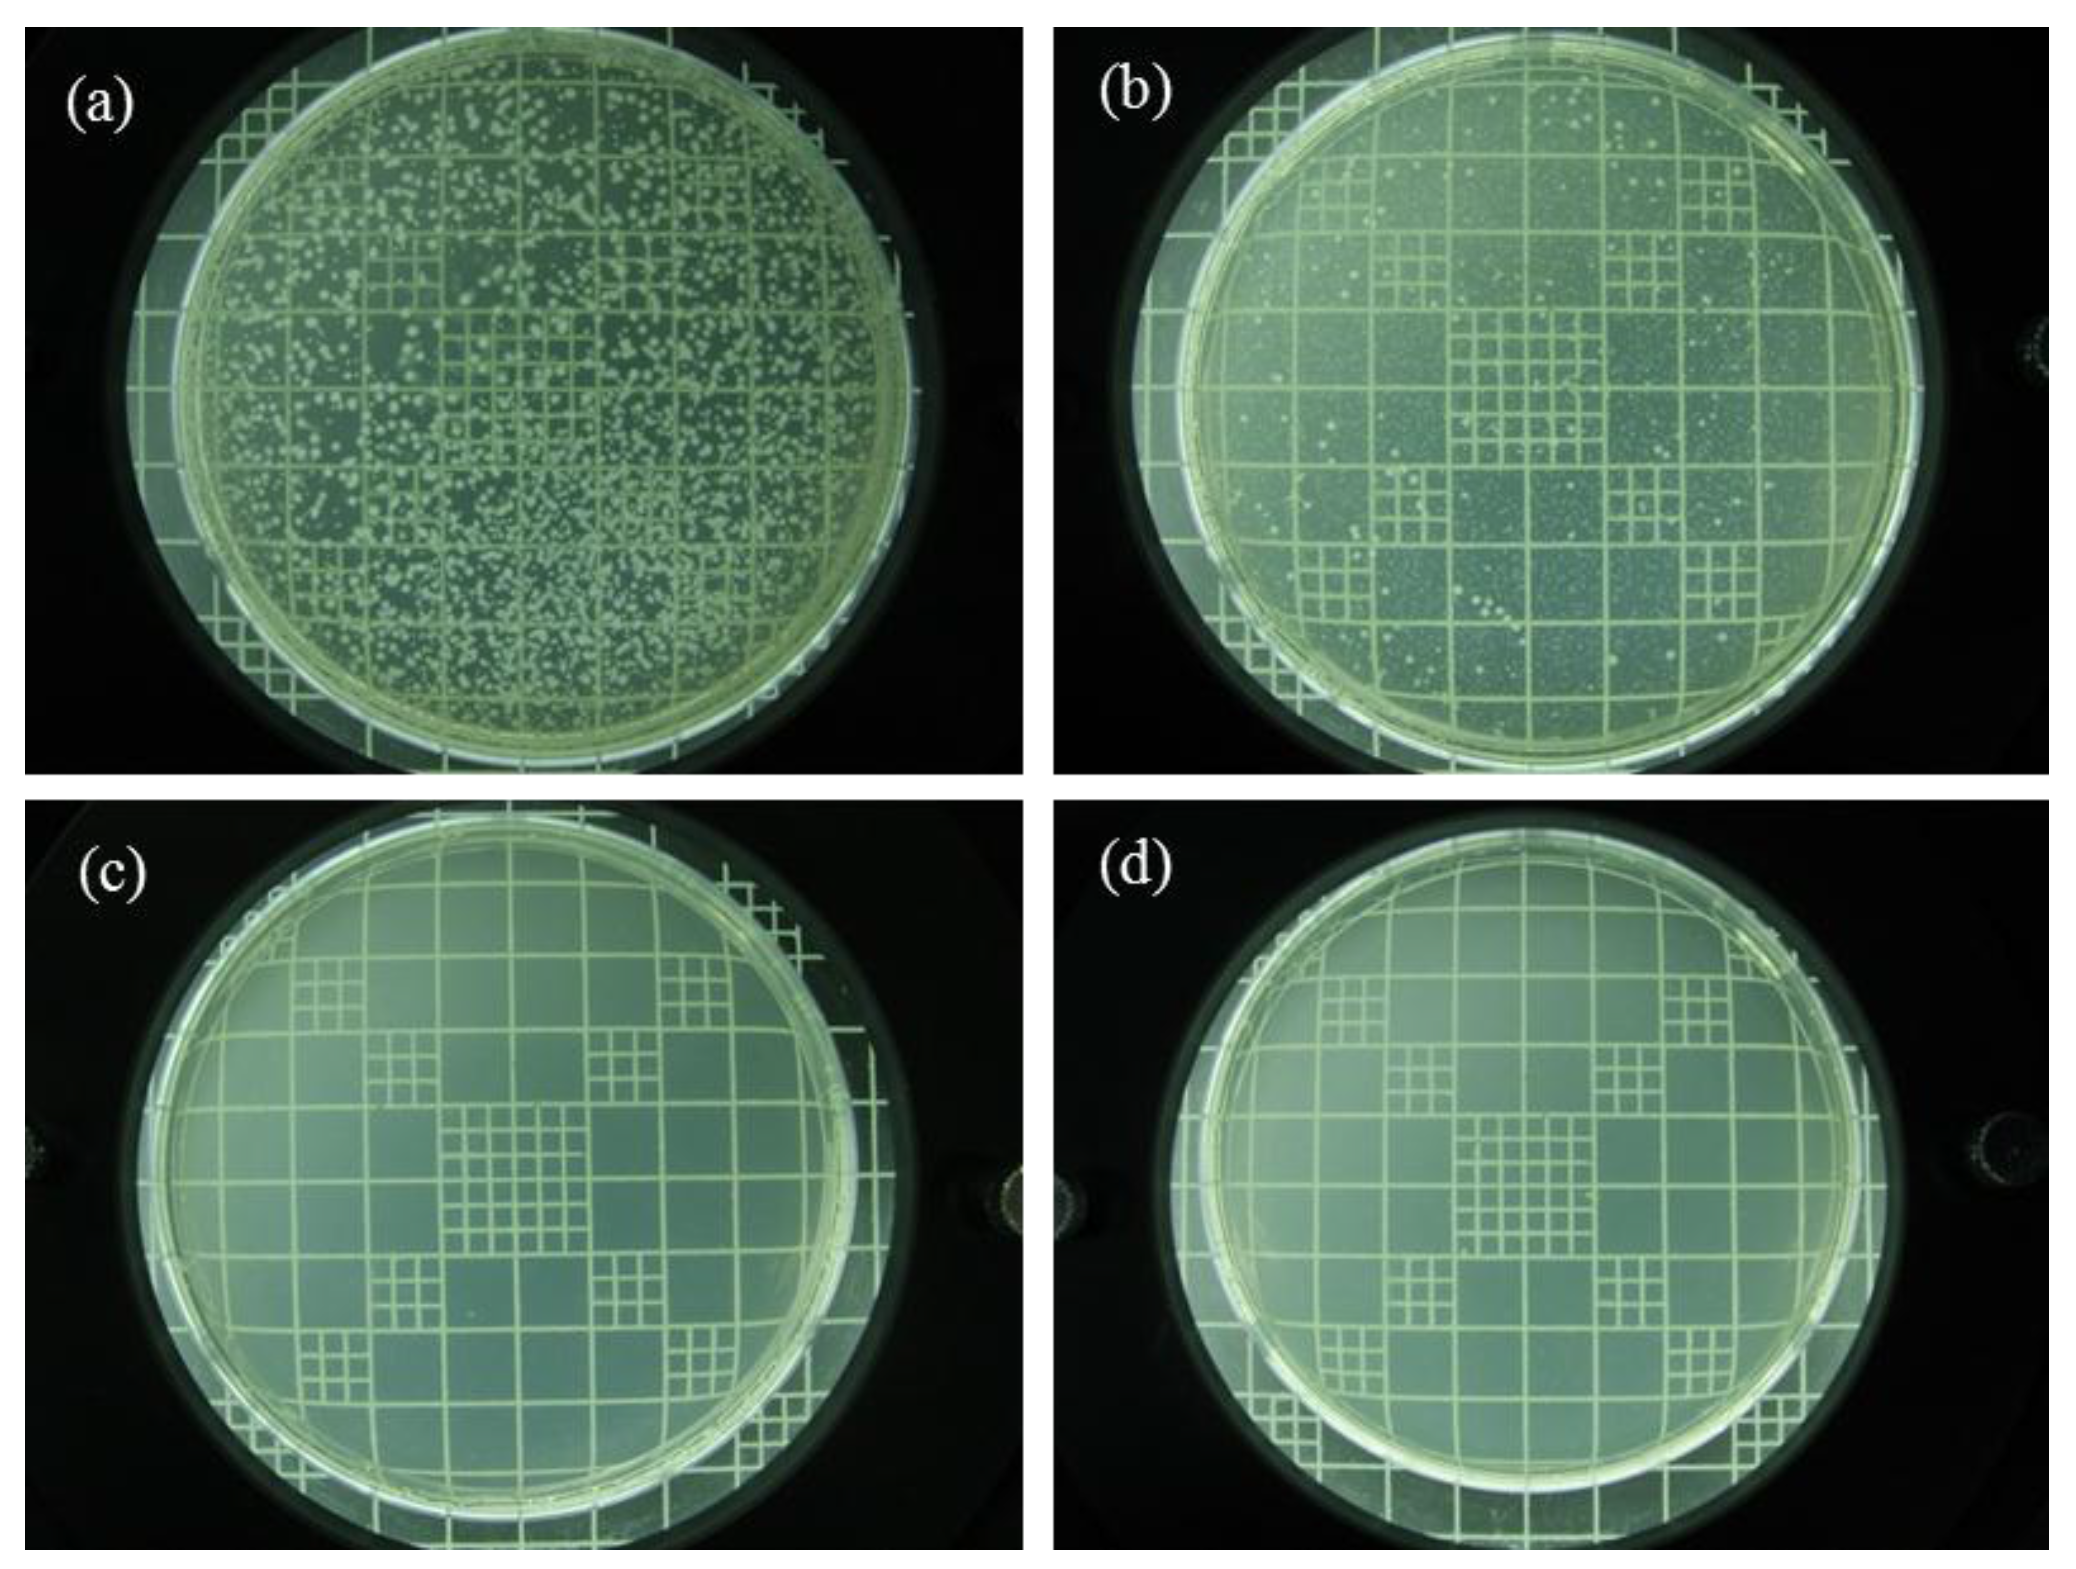

Optimum Conditions for the Fabrication of Zein/Ag Composite Nanoparticles from Ethanol/H2O Co-Solvents Using Electrospinning
Abstract
:1. Introduction
2. Experimental
2.1. Materials
2.2. Preparation of Zein/Ag Blend Solutions
2.3. Electrospinning Process
2.4. Characterization
2.5. Anti-Microbial Performance Test
3. Results and Discussion
3.1. Particle Morphology
3.2. XRD Data
3.3. Thermal Stability
3.4. Antibacterial Efficacy
4. Conclusions
Acknowledgments
Author Contributions
Conflicts of Interest
References
- Ge, X.; Li, M.C.; Li, X.X.; Cho, U.R. Effects of silane coupling agents on the properties of bentonite/nitrile butadiene rubber nanocomposites synthesized by a novel green method. Appl. Clay Sci. 2015, 118, 265–275. [Google Scholar] [CrossRef]
- Chen, B.; Leung, D.Y.C.; Xuan, J.; Wang, H. A high specific capacity membraneless aluminum-air cell operated with an inorganic/organic hybrid electrolyte. J. Power Source 2016, 336, 19–26. [Google Scholar] [CrossRef]
- Feenstra, A.D.; O’Neill, K.C.; Yangik, G.B.; Lee, Y.J. Organic-inorganic binary mixture matrix for comprehensive laser-desorption ionization mass spectrometric analysis and imaging of medium-size molecules including phospholipids, glycerolipids, and oligosaccharides. RSC Adv. 2016, 6, 99260–99268. [Google Scholar] [CrossRef]
- Wu, W.; He, T.; Chen, J.E.; Zheng, X.; Chen, Y. Study on in situ preparation of nano calcium carbonate/PMMA composite particles. Mater. Lett. 2006, 60, 2410–2415. [Google Scholar] [CrossRef]
- Zhang, B.; Luo, Y.; Wang, Q. Development of silver-zein composites as a promising antimicrobial agent. Biomacromolecules 2010, 11, 2366–2375. [Google Scholar] [CrossRef] [PubMed]
- Zhu, Z.K.; Yin, J.; Cao, F.; Shang, X.Y.; Lu, Q.H. Photosensative polyimide/silica hybrids. Adv. Mater. 2000, 12, 1055–1057. [Google Scholar] [CrossRef]
- Miyoshi, T.; Toyohara, K.; Minematsu, H. Preparation of ultrafine fibrous zein membranes via electrospinning. Polym. Int. 2005, 54, 1187–1190. [Google Scholar] [CrossRef]
- Reddy, N.; Yang, Y. Potential of plant proteins for medical applications. Trends Biotechnol. 2011, 29, 490–498. [Google Scholar] [CrossRef] [PubMed]
- Shukla, R.; Cheryan, M. Zein: The industrial protein from corn. Ind. Crop. Prod. 2001, 13, 171–192. [Google Scholar] [CrossRef]
- Torres-Giner, S.; Gimenez, E.; Lagaron, J.M. Characterization of the morphology and thermal properties of zein prolamine nanostructures obtained by electrospinning. Food Hydrocoll. 2008, 22, 601–614. [Google Scholar] [CrossRef]
- Torres-Giner, S.; Lagaron, J.M. Zein-based ultrathin fibers containing ceramic nanofillers obtained by electrospinning. I. Morphology and thermal properties. J. Appl. Polym. Sci. 2010, 118, 778–789. [Google Scholar] [CrossRef]
- Yao, C.; Li, X.; Song, T. Electrospinning and crosslinking of zein nanofiber mats. J. Appl. Polym. Sci. 2007, 103, 380–385. [Google Scholar] [CrossRef]
- Dickey, L.C.; McAloon, A.; Parris, N. Minimizing entrainment of extract liquid by settling maize particles. Ind. Crop. Prod. 2003, 18, 77–84. [Google Scholar] [CrossRef]
- Fu, D.; Weller, C.L. Rheology of zein solutions in aqueous ethanol. J. Agric. Food Chem. 1999, 47, 2103–2108. [Google Scholar] [CrossRef] [PubMed]
- Guo, Y.; Liu, Z.; An, H.; Li, M.; Hu, J. Nano-structure and properties of maize zein studied by atomic force microscopy. J. Cereal Sci. 2005, 41, 277–281. [Google Scholar] [CrossRef]
- Kim, S.; Sessa, D.J.; Lawton, J.W. Characterization of zein modified with a mild cross-linking agent. Ind. Crop. Prod. 2004, 20, 291–300. [Google Scholar] [CrossRef]
- Lawton, J.W. Zein: A history of processing and use. Cereal Chem. 2002, 79, 1–18. [Google Scholar] [CrossRef]
- Parris, N.; Cooke, P.H.; Hicks, K.B. Encapsulation of Essential Oils in Zein Nanospherical Particles. J. Agric. Food Chem. 2005, 53, 4788–4792. [Google Scholar] [CrossRef] [PubMed]
- Argos, P.; Pedersen, K.; Marks, M.D.; Larkins, B.A. A structural model for maize zein proteins. J. Biol. Chem. 1982, 257, 9984–9990. [Google Scholar] [PubMed]
- Dastjerdi, R.; Montazer, M. A review on the application of inorganic nano-structured materials in the modification of textiles: Focus on anti-microbial properties. Colloids Surf. B 2010, 79, 5–18. [Google Scholar] [CrossRef] [PubMed]
- Park, J.H.; Karim, M.R.; Kim, I.K.; Cheong, I.W.; Kim, J.W.; Bae, D.G.; Cho, J.W.; Yeum, J.H. Electrospinning fabrication and characterization of poly(vinyl alcohol)/montmorillonite/silver hybrid nanofibers for antibacterial applications. Colloid Polym. Sci. 2010, 288, 115–121. [Google Scholar] [CrossRef]
- Rujitanaroj, P.O.; Pimpha, N.; Supaphol, P. Wound-dressing materials with antibacterial activity from electrospun gelatin fiber mats containing silver nanoparticles. Polymer 2008, 49, 4723–4732. [Google Scholar] [CrossRef]
- Huang, S.; Zhou, L.; Li, M.C.; Wu, Q.; Kojima, Y.; Zhou, D. Preparation and properties of electrospun poly (vinyl pyrrolidone)/cellulose nanocrystal/silver nanoparticle composite fibers. Materials 2016, 9, 523–536. [Google Scholar] [CrossRef]
- Yang, Q.B.; Li, D.M.; Hong, Y.L.; Li, Z.Y.; Wang, C.; Qiu, S.L.; Wei, Y. Preparation and characterization of a PAN nanofiber containing Ag nanoparticles via electrospinning. Synth. Met. 2003, 137, 973–974. [Google Scholar] [CrossRef]
- Deitzel, J.M.; Kleinmeyer, J.D.; Hirvonen, J.K.; Beck, T.N.C. Controlled deposition of electrospun poly(ethylene oxide) fibers. Polymer 2001, 42, 8163–8170. [Google Scholar] [CrossRef]
- Ding, B.; Li, C.R.; Fujita, S.; Shiratori, S. Formation of novel 2D polymer nanowebs via electrospinning. Nanotechnology 2006, 17, 3685–3691. [Google Scholar] [CrossRef]
- Huang, Z.M.; Zhang, Y.Z.; Kotaki, M.; Ramakrishn, S. A review on polymer nanofibers by electrospinning and their applications in nanocomposites. Compos. Sci. Technol. 2003, 63, 2223–2253. [Google Scholar] [CrossRef]
- Jin, H.J.; Fridrikh, S.V.; Rutledge, G.C.; Kaplan, D.L. Electrospinning Bombyxmori silk with poly(ethylene oxide). Biomacromolecules 2002, 3, 1233–1239. [Google Scholar] [CrossRef] [PubMed]
- Li, W.J.; Laurencin, C.T.; Caterson, E.J.; Tuan, R.S.; Ko, F.K. Electrospun nanofibrous structure: A novel scaffold for tissue engineering. J. Biomed. Mater. Res. 2002, 60, 613–621. [Google Scholar] [CrossRef] [PubMed]
- Li, D.; Xia, Y. Fabrication of titania nanofibers by electrospinning. Nano Lett. 2003, 3, 555–560. [Google Scholar] [CrossRef]
- Li, D.; Xia, Y. Electrospinning of nanofibers: Reinventing the wheel. Adv. Mater. 2004, 16, 1151–1170. [Google Scholar] [CrossRef]
- Reneker, D.H.; Chun, I. Nanometre diameter fibres of polymer, produced by electrospinning. Nanotechnology 1996, 7, 216–223. [Google Scholar] [CrossRef]
- Zong, X.; Li, S.; Chen, E.; Garlick, B.; Kim, K.S.; Fang, D.; Jonathan, C.; Thomas, Z.; Collin, B.; Benjamin, S.H.; et al. Prevention of postsurgery-nduced abdominal adhesions by electrospun bioabsorbable nanofibers poly(lactide-co-glycolide)-based membranes. Ann. Surg. 2004, 240, 910–915. [Google Scholar] [CrossRef] [PubMed]
- Cui, W.; Li, X.; Zhou, S.; Weng, J. Investigation on process parameters of electrospinning system through orthogonal experimental design. J. Appl. Polym. Sci. 2007, 103, 3105–3112. [Google Scholar] [CrossRef]
- Li, L.; Jiang, Z.; Xu, J.; Fang, T. Predicting poly(vinyl pyrrolidone)’s solubility parameter and systematic investigation of the parameters of electrospinning with response surface methodology. J. Appl. Polym. Sci. 2014, 131. [Google Scholar] [CrossRef]
- Ye, X.-Y.; Lin, F.-W.; Huang, X.-J.; Liang, H.-Q.; Xu, Z.-K. Polymer fibers with hierarchically porous structure: combination of high temperature electrospinning and thermally induced phase separation. RSC Adv. 2013, 3, 13851–13858. [Google Scholar] [CrossRef]
- Khanum, K.K.; Sandeep, B.S.; Praveen, C.R. Design and morphology control of a thiophene derivative through electrospraying using various solvents. RSC Adv. 2015, 5, 60419–60425. [Google Scholar] [CrossRef]
- Lee, H.W.; Karim, M.R.; Park, J.H.; Bae, D.G.; Oh, W.; Cheong, I.W.; Yeum, J.H. Electrospinning and characterization of poly(vinyl alcohol) blend submicron fibers in aqueous solutions. Polym. Polym. Compos. 2009, 17, 47–54. [Google Scholar]
- Park, J.H.; Lee, H.W.; Chae, D.K.; Oh, W.; Yun, J.D.; Deng, Y.; Yeum, J.H. Electrospinning and characterization of poly(vinyl alcohol)/chitosan oligosaccharide/clay nanocomposite nanofibers in aqueous solutions. Colloid Polym. Sci. 2009, 287, 943–950. [Google Scholar] [CrossRef]
- Islam, M.S.; Yeum, J.H.; Das, A.K. Effect of pullulan/poly(vinyl alcohol) blend system on the montmorillonite structure with property characterization of electrospun pullulan/poly(vinyl alcohol)/montmorillonite nanofiber. J. Colloid Interf. Sci. 2012, 368, 273–281. [Google Scholar] [CrossRef] [PubMed]
- Rabbani, M.M.; Kim, Y.H.; Yeum, J.H. Effect of co-solvent ratios and solution concentrations on the morphologies of electrospun zein nanomaterials. Curr. Res. Agric. Life Sci. 2013, 31, 11–13. [Google Scholar]
- Shin, Y.N.; Hohman, B.M.P.; Rutletge, G.C. Electrospinning: A whipping fluid jet generates submicron polymer fibers. Appl. Phys. Lett. 2001, 78, 1149–1151. [Google Scholar] [CrossRef]
- Yao, C.; Li, X.; Song, T. Preparation and characterization of zein and zein/poly-l-lactide nanofiber yarns. J. Appl. Polym. Sci. 2009, 114, 2079–2086. [Google Scholar] [CrossRef]
- Lai, H.M.; Geil, P.H.; Padua, G.W. X-ray diffraction characterization of the structure of zein-oleic acid films. J. Appl. Polym. Sci. 1999, 71, 1267–1281. [Google Scholar] [CrossRef]
- Dong, A.G.; Wang, Y.J.; Tang, Y.; Ren, N.; Yang, W.L.; Gao, Z. Fabrication of compact silver nanoshells on polystyrene spheres through electrostatic attraction. Chem. Commun. 2002, 4, 350–351. [Google Scholar] [CrossRef]
- Dowling, D.P.; Donnelly, K.; McConnell, M.L.; Eloy, R.; Arnaud, M.N. Deposition of anti-bacterial silver coatings on polymeric substrates. Thin Solid Films 2001, 398, 602–606. [Google Scholar] [CrossRef]

| Concentration | 10 wt % | 15 wt % | 20 wt % |
|---|---|---|---|
| EtOH/H2O = 7/3 | 8.7 ± 1.6 mPa·s | 20.8 ± 2.6 mPa·s | 38.2 ± 2.7 mPa·s |
| EtOH/H2O = 8/2 | 9.1 ± 1.8 mPa·s | 28.7 ± 2.1 mPa·s | 45.2 ± 3.4 mPa·s |
| EtOH/H2O = 9/1 | 9.8 ± 1.4 mPa·s | 35.1 ± 2.7 mPa·s | 52.1 ± 3.5 mPa·s |
| Ag Concentration | 0 wt % | 2 wt % | 4 wt % |
|---|---|---|---|
| EtOH/H2O = 8/2 | 9.1 ± 1.8 mPa·s | 11.8 ± 2.1 mPa·s | 12.4 ± 2.6 mPa·s |
© 2016 by the authors; licensee MDPI, Basel, Switzerland. This article is an open access article distributed under the terms and conditions of the Creative Commons Attribution (CC-BY) license (http://creativecommons.org/licenses/by/4.0/).
Share and Cite
Yang, S.B.; Rabbani, M.M.; Ji, B.C.; Han, D.-W.; Lee, J.S.; Kim, J.W.; Yeum, J.H. Optimum Conditions for the Fabrication of Zein/Ag Composite Nanoparticles from Ethanol/H2O Co-Solvents Using Electrospinning. Nanomaterials 2016, 6, 230. https://doi.org/10.3390/nano6120230
Yang SB, Rabbani MM, Ji BC, Han D-W, Lee JS, Kim JW, Yeum JH. Optimum Conditions for the Fabrication of Zein/Ag Composite Nanoparticles from Ethanol/H2O Co-Solvents Using Electrospinning. Nanomaterials. 2016; 6(12):230. https://doi.org/10.3390/nano6120230
Chicago/Turabian StyleYang, Seong Baek, Mohammad Mahbub Rabbani, Byung Chul Ji, Dong-Wook Han, Joon Seok Lee, Jong Won Kim, and Jeong Hyun Yeum. 2016. "Optimum Conditions for the Fabrication of Zein/Ag Composite Nanoparticles from Ethanol/H2O Co-Solvents Using Electrospinning" Nanomaterials 6, no. 12: 230. https://doi.org/10.3390/nano6120230
APA StyleYang, S. B., Rabbani, M. M., Ji, B. C., Han, D.-W., Lee, J. S., Kim, J. W., & Yeum, J. H. (2016). Optimum Conditions for the Fabrication of Zein/Ag Composite Nanoparticles from Ethanol/H2O Co-Solvents Using Electrospinning. Nanomaterials, 6(12), 230. https://doi.org/10.3390/nano6120230

